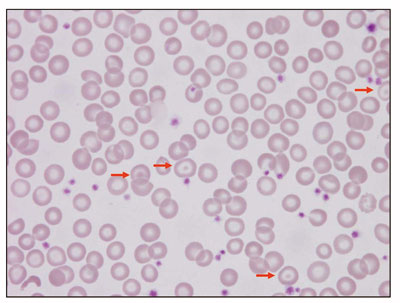
�}3
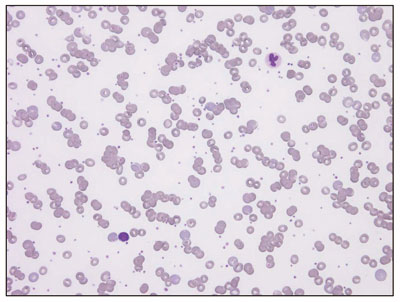
�}5
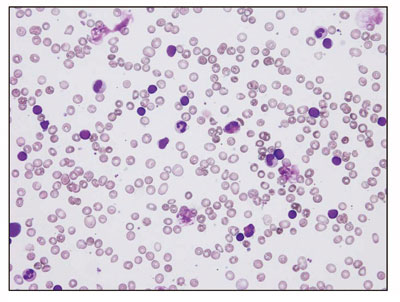
�}6

こどもの貧血-よもやま話-
沖縄県立南部医療センター・こども医療センター小児血液腫瘍科
百名 伸之
【要 旨】
小児科の日常診療で、貧血は最も一般的な血液疾患であり、その大部分は鉄欠乏 によるヘモグロビン産生障害である。小球生低色素性貧血を呈し、鉄剤の補充によ り速やかに改善するので親御さんからは大変感謝される。しかし、時に再燃を繰り 返したり、鉄剤に反応しなかったりすると、小児科医としてはちょっと気まずくな る。さらに貧血以外の所見があったりすると、一気に気が重くなる。往々にして、 重大な疾患が隠れている症例には忘れたころに遭遇するものである。本稿では、こ れまで当センターで経験したこどものさまざまな貧血症例を紹介し、診断に至る過 程、病態生理、治療、その後の経過について述べる。また、一般外来における貧血 診断のフローチャートを提示し、日常診療で診断を誤らないコツをについて述べる。 さらに鉄代謝の最近の知見を紹介し、鉄剤の無用な補充に対して注意を喚起したい。
Ⅰはじめに
貧血は小児血液疾患のなかで最も頻度が高 い。特に鉄欠乏によるヘモグロビン合成障害 は、生理的に鉄需要が大きい乳幼児期、思春期 には一般外来でしばしば遭遇する貧血である。 末梢血液の血算と、血清鉄、総鉄結合能、不飽 和鉄結合能、さらに血清フェリチン値を測定す ることで診断は容易であるが、ときにpit fall に陥ることがある。また鉄欠乏以外の貧血も頻 度は低いものの鑑別診断、治療のうえで重要な ものが多々ある。本稿では実際の症例を提示し ながら小児貧血の日常診療におけるキーポイン トを解説する。また、鉄代謝についての最近の 知見についても述べたい。
Ⅱ症例提示
14 歳の男の子。身長174cm、体重54kg の精 悍な中学生。サッカー部でレギュラーとして活 躍している。ある日、めまい、立ちくらみで開業医を受診した。蒼白顔貌以外の異常は認め ず、血液検査は表1 のようであった。明らかな小球性低色素性貧血であり、血清鉄低下、総鉄 結合能の上昇から鉄欠乏性貧血の診断で鉄剤が開始された。予想通り 速やかに貧血は改善したものの、中止すると再 燃を繰り返すため紹介となった(図1)。さて、 本症例でこのように難治性であったのは如何 なる原因であろうか。鉄欠乏以外の原因がある のであろうか。実はある検査値がフォローされて いなかたったことが原因であった(図2)。フェ リチンは網内系での貯蔵鉄の指標であり、鉄 欠乏性貧血では貯蔵鉄が枯渇しているためフェ リチンが著減している。本例では紹介時に<3ng/ml であり、このた め鉄剤補充を中止すると再燃していたようであ る。このフェリチン値をフォローし、正常化し安 定するまで補充を続けたところ完全に貧血は 回復した。もう一点重要なことは年齢とスポー ツである。思春期は第二の成長期で鉄需要が 増しており、さらにサッカーでの過激な運動で 赤血球寿命も短縮していたのであろう。実際、 部活を引退した後に補充を中止したところ、貧 血の再燃はみられなくなった。鉄欠乏性貧血に ついては以上の点に留意して診療することが重要である。なお、フェ リチン測定(精密)については、保険請求時に鉄欠乏性貧血の病名が 必須である。


図1 治療経過1

図2 治療経過2
【症例2】
2 歳の女の子。5 日間 の発熱、咳、鼻水で急 病センターを受診。肺 炎の診断で入院したが、 貧血が認められた(表 2)。詳細な病歴では以 前から軽い貧血があっ たようだが、精査はされ ていなかった。検査結果 をよく見るとMCV 52fl と極端な小球性である。 しかもRBC は高く、血 清鉄、フェリチンは正常 である。すなわち、本症 例は非鉄欠乏性小球性 貧血という範疇に入り そうである。末梢血標 本をみると特徴的な標 的赤血球が散見された (図3)。さらに家族歴を 詳細に聴取すると、父、 父方叔母、父方従兄弟 に貧血があるという。し かも、叔母のひとりは新 生児期に重症黄疸の既 往、もうひとりは妊娠中 重度の貧血で鉄剤静注 にも不応であったとのこ と。これらから、何らか の遺伝性のヘモグロビン 異常を疑ってヘモグロビ ン分析を行なったところ、HbF およびHbA2 の 上昇が判明した(図4)。すなわちβサラセミア が疑われたのである。確定のため遺伝子解析を 行なったところβグロビン遺伝子のコドン15 (TGG)→ TAG のヘテロの変異が認められた。 これは停止コドンであり、β0サラセミアの診 断が確定した。本症例では重要な点がいくつか挙げられる。まず家族の非鉄欠乏性貧血の鑑別 診断がなされていなかったこと。とくに叔母は 鉄剤の静注まで受けており、その前にある程度 の鑑別診断を行なうべきであった。軽症サラセ ミアは妊娠で一過性に増悪するので要注意であ る。診断の手がかりは極端な小球性貧血であ る。鉄欠乏との鑑別のための指標は様々なものが報告されているが1)、臨床上有用なものは MCV/RBC(× 106/μ l)である。この値が< 13 のときはサラセミアの可 能性が高く、本例でも 53/5.65 = 9.38 であった。 ヘテロの変異ではβグロビン は理論的に正常の半量は産 生されるので貧血は軽度で あり、見逃されているケース が多いと思われる。留意すべ きことは、サラセミアでは通 常鉄過剰状態にあり、鉄剤 補充はむしろ禁忌ということ である。無効で有害な治療 を避けるためにも、早期に診 断を確定することは重要で ある。日本人におけるヘテロ 接合保因者の頻度は1,000 人に1人といわれており2)、 けっしてまれな疾患ではな い。ちなみに、当センター開 院後の1年半ですでに3家系 を診断している。

図3 末梢血液塗抹標本

図4 ヘモグロビン分析結果
【症例3】
5 歳の男の子。既往歴は特 にない。発熱、咳があり風邪 との診断。しかしその後も発 熱が6 日間続き、活気なく顔 色が悪いため再受診。この とき肝腫大と高度の貧血が 認められ、血液腫瘍を疑わ れて紹介となった。検査所 見では(表3)、正球性正色 素性貧血、網状赤血球増加、 間接ビリルビン上昇、LDH 上昇があり、他の血球異常 はみられなかった。骨髄穿刺 では異常細胞を認めず、赤 芽球系は過形成であった。 以上の結果から溶血性貧血 を考えて追加検査を行なっ た。ハプトグロビンは< 10mg/dl と低下し、直 接クームス試験陽性から免疫性溶血性貧血と考え、さらに寒冷凝集素128 倍、マイコプラズマ 抗体80 倍より、マイコプラズマ感染症に続発 する寒冷凝集素症と診断した。末梢血液像は連 銭形成を呈しており(図5)、免疫性溶血性貧 血に特徴的であった。本症例では、臨床症状か ら腫瘍性疾患が疑われたが、一般検査で溶血性 貧血の診断は容易であった。以下、寒冷凝集素 性溶血性貧血について述べ る。定義:自己赤血球に対 する冷式抗体(寒冷凝集素) が増加し、これにより溶血性 貧血をきたす。分類:特発 性はほとんど成人で、まれで ある。続発性はマイコプラズ マ肺炎、ウイルス感染、伝 染性単核症によるものが多 い。病因:自己抗体はIgM クラスに属し、補体結合性 がある。認識抗原はIi 式血 液型物質。病態:身体の寒 冷暴露→赤血球が寒冷凝集 素と結合→補体結合→血管 内、肝臓での破壊。診断: 正球性正色素性貧血、網状 赤血球増加、肝腫大。寒冷 凝集素上昇は512 倍以上で あるが、それ以下のこともあ る。本症例では肝腫大がやは り特徴的であった。また、末 梢血標本の連銭形成も重要な 所見であり、できれば検鏡の 習慣をつけたい。溶血は自然 に回復するが、重症の場合は ステロイドが有効である。本 症例もプレドニン2mg/kg 内 服で速やかに改善し、以後再 燃はみられていない。

図5 末梢血液塗抹標本
【症例4】
生後2 か月の男児。周生 期、家族歴は特記事項なし。 生後早期より白血球減少で紹介されたが、好中球>500/μlで感染所見な く、経過観察していたが、白血球は徐々に回復 していた。ところが生後2 か月のある日、発 熱、活気・哺乳不良で急病センターを受診。採 血で高度の貧血が認められた(表4)大球性正 色素性で、網状赤血球は増加しておらず、鉄欠 乏もみられない。LDH の上昇もなく溶血は否定的で、白血球も再度低下していることから、 造血障害が疑われた。ただちに骨髄穿刺を行な ったところ、赤芽球の著明な低形成が明らかと なる(図6)。血清エリスロポイエチンも8,300 mIU/ml と著増しており、無効造血の所見であ った。以上よりDimond-Blackfan 貧血と診断 した。プレドニンを開始たところ、速やかに反応し、開始後3 週間でHb > 10g/dl となり、5か月で減量 中止し経過観察中である。な お白血球減少もDiamond-Blackfan 貧血に合併する所見 と考えられた。本疾患は新生 児から乳児早期に発症する原 因不明の先天性赤芽球癆であ る。貧血に加え、成長障害、 心奇形、骨格異常、発達遅滞 などを合併することがある。 ステロイド療法が第一選択で るが、無効の場合は輸血依存 となり、鉄過剰症が問題とな る。現在のところ造血幹細胞 移植が唯一の根治療法であ る。欧米では約25 %の症例 に、リボゾーム蛋白S19(RPS19)の遺伝子 変異が認められている3)。RPS19の機能不全 が赤芽球の分化障害きたしていることがin virtroでは明らかにされているが、その機序は いまだ不明である。なお本邦では遺伝子変異の 文献上の報告例はない4)。およそ100 万出生に 4 ~ 5 人のまれな疾患ではあるが、造血障害の機序解明の点からも 小児期の重要な貧血 である。
以上、典型的症例 を提示したが、基本 的知識があればこど もの貧血の鑑別はけ っして困難ではない。 ここで一般小児外来 における診断のフロ ーチャートを示す (図7)。小児では貧 血を主訴として受診 することは少ない。 むしろ急性感染症等 で採血した際に偶然 発見されることも多 く注意を要する。貧 血が確認されれば病 歴、家族歴、診察所 見から原疾患を推測し、赤血球恒数、網状赤血 球数、赤血球形態から貧血の病態を考える。そ のうえで緊急性、入院適応の有無を判断し、た だちに血液専門医を紹介することが肝要である。

有核細胞数70000/μ l、巨核球16/μ l、M/E46.5
骨髄系18.6 %、赤芽球系0.4 %、リンパ球81.0 %
図6 骨髄塗抹標本

図7 主な貧血の診断フローチャート
Ⅲ鉄代謝についての話題
近年、生体内の鉄代謝いついてその詳細が明 らかにされつつある。ここでは、貧血を診療す る上で重要と思われる点について概説したい。
図8 は、鉄の吸収、利用、喪失の概要を示し ている5)。経口摂取された3 価鉄は、小腸上皮 においてD c y t b により2 価鉄に還元され、 dimetal tranporter1(DMT1)によって取り 込まれる。次いで上皮の血管側にあるferoportin1 により血液中に運搬され、hephaestin で3 価鉄となってトランスフェリンに結合し、 血清鉄となる。血清鉄は骨髄の赤芽球にtranferin receptor1(TfR1)-HFE-β2 ミクログ ロブリン複合体により取り込まれ、ヘム鉄とな ってヘモグロビン合成に利用される。血清鉄の 一部は肝臓において肝細胞に取り込まれ、フェ リチンとして貯蔵鉄となる。一方、古くなった 赤血球は網内系のマクロファージに貪食され、 遊離した鉄はferoportin1 により血中に放出さ れて血清鉄となり再利用される。体内の鉄は、 腸管上皮の脱落や生理などにより不可避的に喪 失する。鉄代謝は、このように生体内で閉鎖回 路を形成しており、能動的に排泄する機構は備 わっていない。この点が重要で、過剰な鉄は肝 臓や心筋に蓄積し、臓器障害を引き起こす。し たがって、非鉄欠乏性貧血患者に対して鉄剤を 補充することは禁忌である。一方、鉄欠乏状態 では貧血をきたすが、貯蔵鉄の再利用でただち に貧血とはならない。ただし小児では、このよ うな潜在的鉄欠乏において神経学的および行動 異常をまねく恐れがあることが報告されており 6)、注意を要する。
最後に、最近注目されているhepcidin につ いて述べる。消化管での吸収と網内系からの放 出は造血状態や鉄貯蔵状態で調節されているこ とは上述したが、生体内でこれら調節を担う液 性因子の存在が推測されていた。2000 ~ 2001年に内因性抗菌ペプチドとしてhepcidin が発 見されたが、これが鉄過剰状態で肝臓で誘導さ れることが分かった。さらにhepcidin を過剰 発現させたマウスは極度の貧血で死亡すること が証明され、これによりhepcidin こそが鉄調 節ホルモンであると考えられている(図9)7)。 小児でしばしばみられる炎症性疾患に伴う貧血 は、リポ多糖やIL-6 により肝臓でのhepcidin 産生が亢進し、鉄の網内系への蓄積と吸収抑制 により血清鉄が減少して生ずることが理解され る。また、遺伝性ヘモクロマトーシスにおける hepcidin の関与について、現在研究が進んでい るところである。
貧血と鉄代謝は、古く て新しいテーマであり、 日常診療に密接に関わる ものである。本稿により、 この分野についてあらた めて理解が深まり、興味 をもって診療にあたって いただければ幸いである。
謝辞:ヘモグロビン分析 とサラセミア遺伝子解析 を行なっていただいた川 崎医療福祉大学、原野恵 子先生に深謝致します。

図8 生体内での鉄動態(生田ら、Annal Review2006,)

図9 Hepcidin による鉄代謝の調節(Fleming RE, et al. Proc Natl Acad Sci U S A, 2001.)
1)肝細胞での血清鉄の取り込み増加、リポ多糖体(LPS)への暴露、2)Hepcidin の産生、分
泌増加、3)網内系(RE)マクロファージ、陰窩細胞による鉄取り込みと蓄積増加、4)陰窩細
胞の腸絨毛細胞への分化と鉄移送蛋白の発現低下、5)食事中鉄の吸収低下。
文献
1)Beyan C, et al:Predictive
value of discrimination
indices in differential
diagnosis of iron deficiency
anemia and beta-thalassemia
trait.Eur J Haematol. 2007
Jun;78(6):524-6.
2)Imamura T, et al: Thalassemia
in Japan,Nippon Ketsueki
Gakkai Zasshi, 48:2029-37.
1985 .
3)Gazda HT, Sieff CA. Recent insights into the
pathogenesis of Diamond?Blackfan anaemia.
4)Ohga S, et al: Diamond-Blackfan anemia in Japan:
clinical outcomes of prednisolone therapy and
hematopoietic stem cell transplantation, Int J
Hematol. 79:22-30,2004.
5)生田克哉,他:鉄関連分子の同定とその機能,高久史
麿編,Annual Review 血液,中外医学社,東京,
2006;80-88.
6)Yager JY, Hartfield DS.;Neurologic manifestations of
iron deficiency in childhood. Pediatr Neurol 27:85-92,
2002.
7)Fleming RE, Sly WS.:Hepcidin: a putative ironregulatory
hormone relevant to hereditary
hemochromatosis and the anemia of chronic disease.
Proc Natl Acad Sci U S A 98:8160-2, 2001.
著 者 紹 介

沖縄県立南部医療センター・こども医療センター
小児血液腫瘍科 百名 伸之生年月日:昭和33 年10月6日
出身地:沖縄県 那覇市
出身大学:北海道大学医学部 昭和60年卒
略歴
昭和60年3月 北海道大学医学部医学科卒業
昭和60年6月 琉球大学医学部附属病院医員(研修医)
昭和61年12月 与那原中央病院 医師
昭和62年6月 琉球大学医学部附属病院医員
昭和63年1月 沖縄県立宮古病院医師
平成1年4月 琉球大学医学部附属病院医員
平成2年9月 琉球大学医学部小児科助手
平成11年8月 琉球大学医学部小児科講師
平成13年9月 米国ベイラ-医科大学留学
平成14年8月 琉球大学医学部小児科助教授
平成17年12月 沖縄県立那覇病院小児科副部長
平成18年4月~ 沖縄県立南部医療センター・こども医療センター 小児血液腫瘍科 部長専攻・診療領域
小児科・血液腫瘍その他・趣味等
JAZZ ・ギター・読書・自転車
Q U E S T I O N !
問題:鉄欠乏性貧血について誤っているのはど れか。
- a. 小児では乳児期、思春期に多くみられる。
- b. 小球性低色素性貧血をきたす。
- c. MCV/RBC(× 106/μ l)<13 のときは、サラセミアを疑う。
- d. フェリチンは正常以下に低下している。
- e. 鉄剤補充はヘモグロビン値が正常化した時点で終了する。
CORRECT ANSWER! 11月号(vol.43)の正解
問題:新生児の体外式膜型人工肺(ECMO)に ついて間違っているものをひとつ選んで ください
- 1)一酸化窒素吸入療法(iNO)は保険適応が ないので治療選択としてはECMO が優先さ れる
- 2)ECMO は生命補助装置であって、原疾患に 対する直接的な治療効果はない
- 3)ECMO は重篤な循環障害時の循環補助とし ても用いられる
- 4)ECMO は沖縄県における先天性横隔膜ヘル ニアの予後改善の一因である
正解 1)